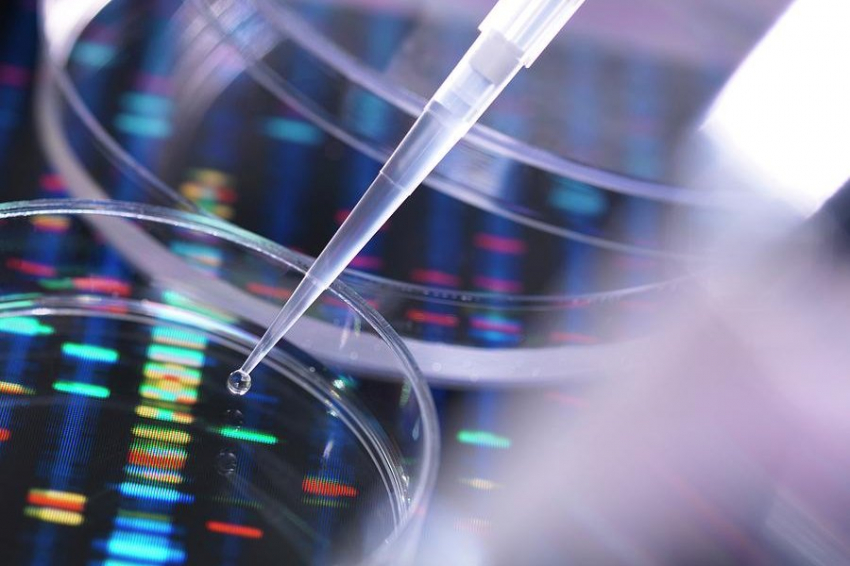
Ученые назвали распространенную ошибку при лечении рака

Важные события в Военной Хронике за сегодня 18.06.23
18 июня Юрий Подоляка представляет последние новости и сводки о ходе спецоперации на Украине. Поездка Альбанезе в Мадрид, которая включала встречу с Зеленским на Украине, состоялась чуть более чем через месяц после того, как лейбористы сформировали правительство. Это было в довершение стремления Альбанезе в свой первый полный рабочий день в должности посетить саммит четырех стран в Токио, чтобы присоединиться к Байдену и премьер-министрам Японии и Индии для обсуждения усиления конфронтации с